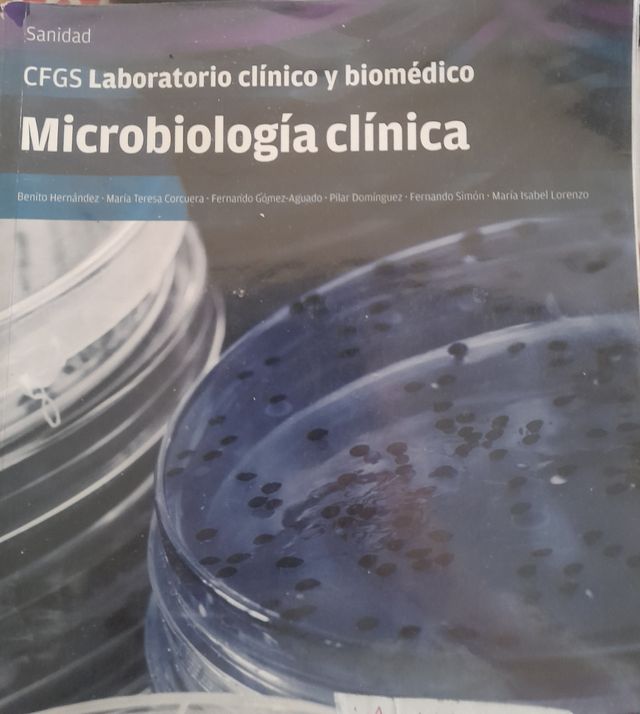
Microbiología clínica

Arantxa
43 Ventas29 Compras
28030, Madrid
- 50 €
Zapatos de tacón y cuña dorados y beige
- 2 €
Sudadera Rams Talla S mujer/niño
10 €Tara Jarmon Camisa Seda Beige Talla 38
- 5 €
Objectif Express - Nouvelle Edition: Livre De L...
- 5 €
Faldas Padel invierno
- 5 €
Portatrajes Marcas FulHam, Hackett, Scalpers,Marni
- 100 €
Manta Chal Agnona Alpaca y Lana Original 1500eu
- 1 €
Bufandas, Gorros, Guantes y Pañuelos de marca
- 5 €
Pañuelos Armani Seda otros
- 5 €
Lote 5eu piezas invierno: gorros, guantes, bufanda
80 €Bolso Zadig & Voltaire Calaveras original 500eu
- 5 €
Bolsa Bimba y Lola Blanca Piamonte Vince Ash Zadig
- 5 €
Bolsa de tela Oli & Carol beige
- 100 €
Bolso Prada original Cuero Marrón original 3000eu
50 €Bolso Hombro Dominique Picquier Azul origal 300eu
- 8 €
mp3 codificador y descodificador
- 13 €
Microbiología clínica
3 €Kama Sutra, Herotica, Massage en Inglés
- 3 €
I, Robot, Juan Salvador Gaviota, Como un espejismo
- 35 €
chaqueta Bici Inverse
- 5 €
Cargador macbookPro 60w
- 15 €
Nevir Dvd coche
- 10 €
Laminadora
- 15 €
soporte Dvd coche
- 50 €
Zapatos de tacón y cuña Kenneth Cole Prada Marni
- 20 €
Zapatos de tacón y planos marcas
- 30 €
Lote de Zapatos Variados
5 €Sudadera Negra XL Just Hoods Revolut
- 5 €
Camisas hombre cuadros de marca L M
5 €Massimo Dutti Jersey Pico Azul Talla M
- 20 €
Chaqueta Dustin Lana Gris Talla L forrada
- 10 €
Pantalón vaquero pana hombre 42
10 €Chaqueta Lana Azul Massimo Dutti Talla M
50 €Chaqueta hombre Shon Mott Talla L
- 50 €
Chaqueta Pedro del Hierro Marrón Talla L
- 12 €
Chaqueta Vespa Negra Talla M
- 30 €
Chaqueta Uniqlo Mujer Talla S
- 75 €
Chaqueta El Ganso Talla 46
15 €Pantalón Hugo Boss Mujer Talla 38 Beige
50 €Vestidos Negro y Beige